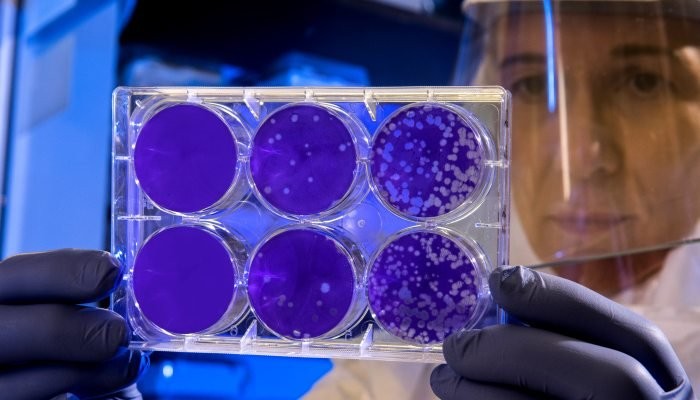
covid-1.jpg

ΔΕΙΤΕ ΕΔΩ.
Novibet ΕΠΑΘΑ με Super Προσφορά* Γνωριμίας* 21+ | ΑΡΜΟΔΙΟΣ ΡΥΘΜΙΣΤΗΣ: ΕΕΕΠ | ΚΙΝΔΥΝΟΣ ΕΘΙΣΜΟΥ & ΑΠΩΛΕΙΑΣ ΠΕΡΙΟΥΣΙΑΣ | ΓΡΑΜΜΗ ΒΟΗΘΕΙΑΣ ΚΕΘΕΑ: 2109237777 | ΠΑΙΞΕ ΥΠΕΥΘΥΝΑ
SEAJETS Ταξιδεύουμε μαζί με το μεγαλύτερο στόλο ταχύπλοων παγκοσμίως σε 50 προορισμούς του Αιγαίου!